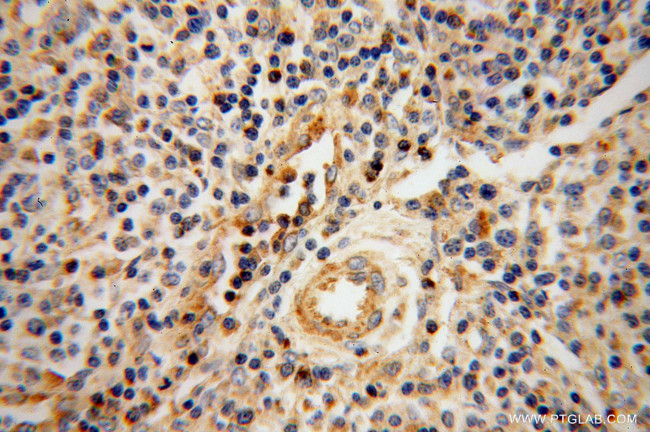
Granzyme A Antibody in Immunohistochemistry (Paraffin) (IHC (P))

Search
Proteintech
Granzyme A Polyclonal Antibody
{{$productOrderCtrl.translations['antibody.pdp.commerceCard.promotion.promotions']}}
{{$productOrderCtrl.translations['antibody.pdp.commerceCard.promotion.viewpromo']}}
{{$productOrderCtrl.translations['antibody.pdp.commerceCard.promotion.promocode']}}: {{promo.promoCode}} {{promo.promoTitle}} {{promo.promoDescription}}. {{$productOrderCtrl.translations['antibody.pdp.commerceCard.promotion.learnmore']}}
产品信息
11288-1-AP
种属反应
已发表种属
宿主/亚型
分类
类型
抗原
偶联物
形式
浓度
规格
纯化类型
保存液
内含物
保存条件
运输条件
产品详细信息
Immunogen sequence: MRNSYRFLA SSLSVVVSLL LIPEDVCEKI IGGNEVTPHS RPYMVLLSLD RKTICAGALI AKDWVLTAAH CNLNKRSQVI LGAHSITREE PTKQIMLVKK EFPYPCYDPA TREGDLKLLQ LTEKAKINKY VTILHLPKKG DDVKPGTMCQ VAGWGRTHNS ASWSDTLREV NITIIDRKVC NDRNHYNFNP VIGMNMVCAG SLRGGRDSCN GDSGSPLLCE GVFRGVTSFG LENKCGDPRG PGVYILLSKK HLNWIIMTIK GAV (1-262 aa encoded by BC015739)
靶标信息
Cytolytic T lymphocytes (CTL) and natural killer (NK) cells share the remarkable ability to recognize, bind, and lyse specific target cells. They are thought to protect their host by lysing cells bearing on their surface 'nonself' antigens, usually peptides or proteins resulting from infection by intracellular pathogens. The protein described here is a T cell- and natural killer cell-specific serine protease that may function as a common component necessary for lysis of target cells by cytotoxic T lymphocytes and natural killer cells.
仅用于科研。不用于诊断过程。未经明确授权不得转售。
生物信息学
蛋白别名: Autocrine thymic lymphoma granzyme-like serine protease; BLT esterase; CTL tryptase; CTLA-3; Cytotoxic T-lymphocyte proteinase 1; Cytotoxic T-lymphocyte-associated serine esterase-3; Fragmentin-1; granzyme 1; Granzyme A; Granzyme A (Cytotoxic T-lymphocyte-associated serine esterase-3; Hanukah factor serine protease); granzyme A (granzyme 1, cytotoxic T-lymphocyte-associated serine esterase 3); Granzyme-1; GZMA; H factor; Hanukah factor; Hanukah factor serine protease precursor; Hanukah factor serine protease); Hanukkah factor; HF; serine esterase 1; T cell-specific serine protease 1; TSP-1
基因别名: AW494114; Ctla-3; CTLA3; GZMA; Hf; HFSP; Mtsp-1; SE1; TSP-1; TSP1
UniProt ID: (Human) P12544, (Mouse) P11032
Entrez Gene ID: (Human) 3001, (Mouse) 14938